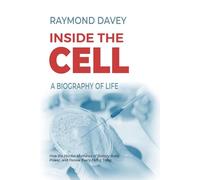
Inside the Cell. A Biography of Life: How the Hidden Machines of Biology Build, Power, and Renew Every Living Thing

![Inside the Living Body [USA] [DVD]](https://cdn.comparar.net/offer/es/inside-the-living-body-usa-dvd-200t18038d7b5c28b783fd5c4f8662beb5ae6ee2d83221d.jpg)

- 1
- 2
- 3
- 4
- 5
- página siguiente
🤖 Pregunta a ChatGPT
Información acerca de "living inside the"
Aquí puedes comparar el precio de venta online para tu búsqueda de "living inside the" y así encontrar la mejor oferta.
De acuerdo con tu búsqueda "living inside the", hemos encontrado el producto que te interesa en 11 categorías.
Datos de "living inside the"
- Consulta los mejores precios de 5 tiendas diferentes, como Amazon Marketplace (ES), amazon.es, Gameseal Spain y casadellibro.com.
- Comparar.net ha encontrado 5 tiendas que ofrecen este artículo. Destacan tiendas como Amazon Marketplace (ES), amazon.es, Gameseal Spain y casadellibro.com.
- 6 proveedores ofrecen el producto buscado - Por ejemplo, Generic Sports, Generique, Square Enix y Generisch.
- Nuestros usuarios han visto las ofertas siguientes: .
- El número de opciones también es grande a la hora de elegir el color: De entre los 0 colores disponibles, puedes seleccionar tu favorito. El mayor número de ofertas está disponible en .